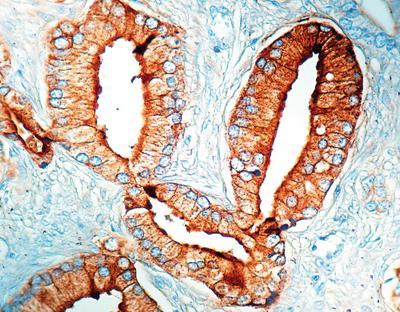

Psap Conc. Mab 1ml ,Each
$ 603.48
|
|
Details:
PSAP^ Clone number PASE/4LJ, This antibody is specific to human prostatic acid phosphatase. It reacts with the glandular epithelium of normal and hyperplastic prostate and with prostate adenocarcinoma. It does not show any cross-reactivity with PSAP from dog, rabbit and rat. .
Additional Information
| SKU | 2321018 |
|---|---|
| UOM | EACH |
| UNSPSC | 12352203 |
| Manufacturer Part Number | MOB 085 |
| Product Dimensions | 8X5X4 Inches |
| Product Weight | 1 |

